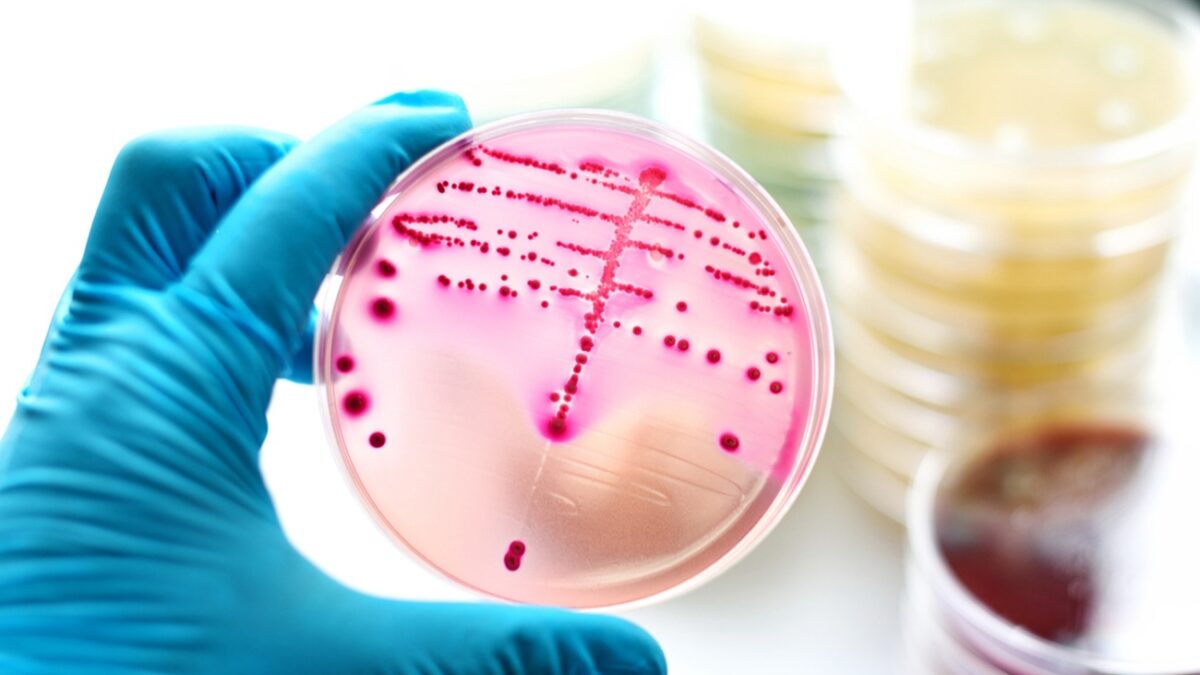
iStock

Επαναστατική μέθοδος δημιουργίας μιας ομάδας ενώσεων με αντικαρκινική, αντι-HIV, αντιδιαβητική και αντιφλεγμονώδη δράση από βιοτεχνολογικά επεξεργασμένα βακτήρια E. coli. Τα φυτά παράγουν πολλές ουσίες με υποσχόμενη φαρμακολογική δράση.
Μάλιστα, είδη του ροδόδενδρου παράγουν μια κατηγορία ενώσεων με αξιοσημείωτες αντικαρκινικές, αντι-HIV, αντιδιαβητικές και αντιφλεγμονώδεις ιδιότητες. Όμως, η φυσική τους προέλευση καθιστά ασταθή και δαπανηρή την παραγωγή τους, ενώ προηγούμενες προσπάθειες μικροβιακής παραγωγής της βασικής ένωσης, του ορσελινικού οξέος, είχαν αποδώσει απογοητευτικά χαμηλές ποσότητες. Συνδυάζοντας την εισαγωγή κατάλληλων γονιδίων από φυτά, μύκητες και βακτήρια, την ανάλυση του μεταβολισμού του οργανισμού και τη βελτιστοποίηση των συνθηκών καλλιέργειας, οι ερευνητές επιδίωξαν να δημιουργήσουν την πρώτη πλατφόρμα παραγωγής αυτών των ενώσεων, με βάση το βακτήριο E. coli.
ΔΙΑΦΗΜΙΣΗ
Σε δημοσίευση στο επιστημονικό περιοδικό «Metabolic Engineering», οι ερευνητές του ιαπωνικού Πανεπιστημίου Kobe περιέγραψαν ότι πέτυχαν παραγωγή 202 mg ορσελινικού οξέος ανά λίτρο, επίδοση που αντιστοιχεί σε βελτίωση κατά 40 φορές σε σχέση με τις προηγούμενες αναφορές μικροβιακής παραγωγής. Πρόκειται όχι μόνο για το υψηλότερο επίπεδο παραγωγής που έχει επιτευχθεί μέχρι σήμερα, αλλά και για την πρώτη φορά που η βασική αυτή ένωση παράχθηκε σε E. coli!

Επιπλέον, η ομάδα εισήγαγε ένα ακόμη γονίδιο από ροδόδενδρο, που ολοκλήρωσε τη βιοσύνθεση μιας φαρμακολογικά σημαντικής ένωσης. Ως αντιπροσωπευτικό παράδειγμα της κατηγορίας των φαρμακευτικών προϊόντων, οι ερευνητές επέλεξαν το γκριφολικό οξύ, γνωστό για τις ισχυρές αντικαρκινικές και αναλγητικές του ιδιότητες.
Αν και τα βακτήρια που δημιουργήθηκαν μπόρεσαν να παράγουν με επιτυχία την ένωση-στόχο, η απόδοση παρέμεινε χαμηλή, με την ερευνητική ομάδα να αναγνωρίζει την ανάγκη περαιτέρω βελτιστοποίησης της διαδικασίας.
Ο επικεφαλής της ερευνητικής ομάδας, Τομοχίσα Χασουνούμα, εξηγεί ότι «βραχυπρόθεσμα, η πλατφόρμα που αναπτύχθηκε μπορεί να εφαρμοστεί άμεσα για την παραγωγή και αξιολόγηση συγγενών ενώσεων και παραγώγων τους. Μακροπρόθεσμα, η στρατηγική ορθολογικού σχεδιασμού που χρησιμοποιήσαμε αποτελεί θεμελιώδη τεχνολογία για την παραγωγή ποικίλων σύνθετων ενώσεων με τη χρήση του E. coli».